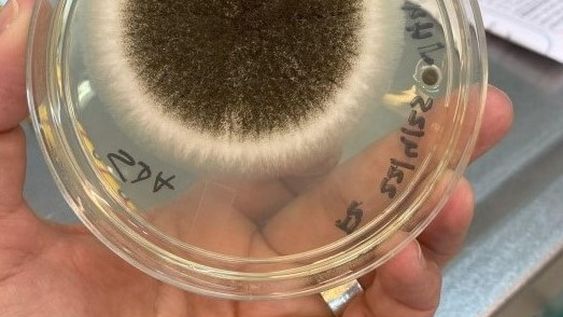
Crecimiento microbiano en medio de cultivo sólido a partir de muestra tomada del aire en salón de escuela. Crecimiento microbiano en medio de cultivo sólido a partir de muestra tomada del aire en salón de escuela.

Noticias sobre Universidad de la República
La Universidad de la República (Udelar) es la principal universidad pública y la más grande de Uruguay, fundada el 18 de julio de 1849 en Montevideo. Cuenta con dieciséis facultades, varias escuelas, campus regionales e institutos universitarios, y ofrece educación superior gratuita y de calidad en diversas áreas del conocimiento. Es una institución autónoma y cogobernada por docentes, estudiantes y egresados, con una misión centrada en la enseñanza, la investigación y la extensión para contribuir al desarrollo social y cultural del país.